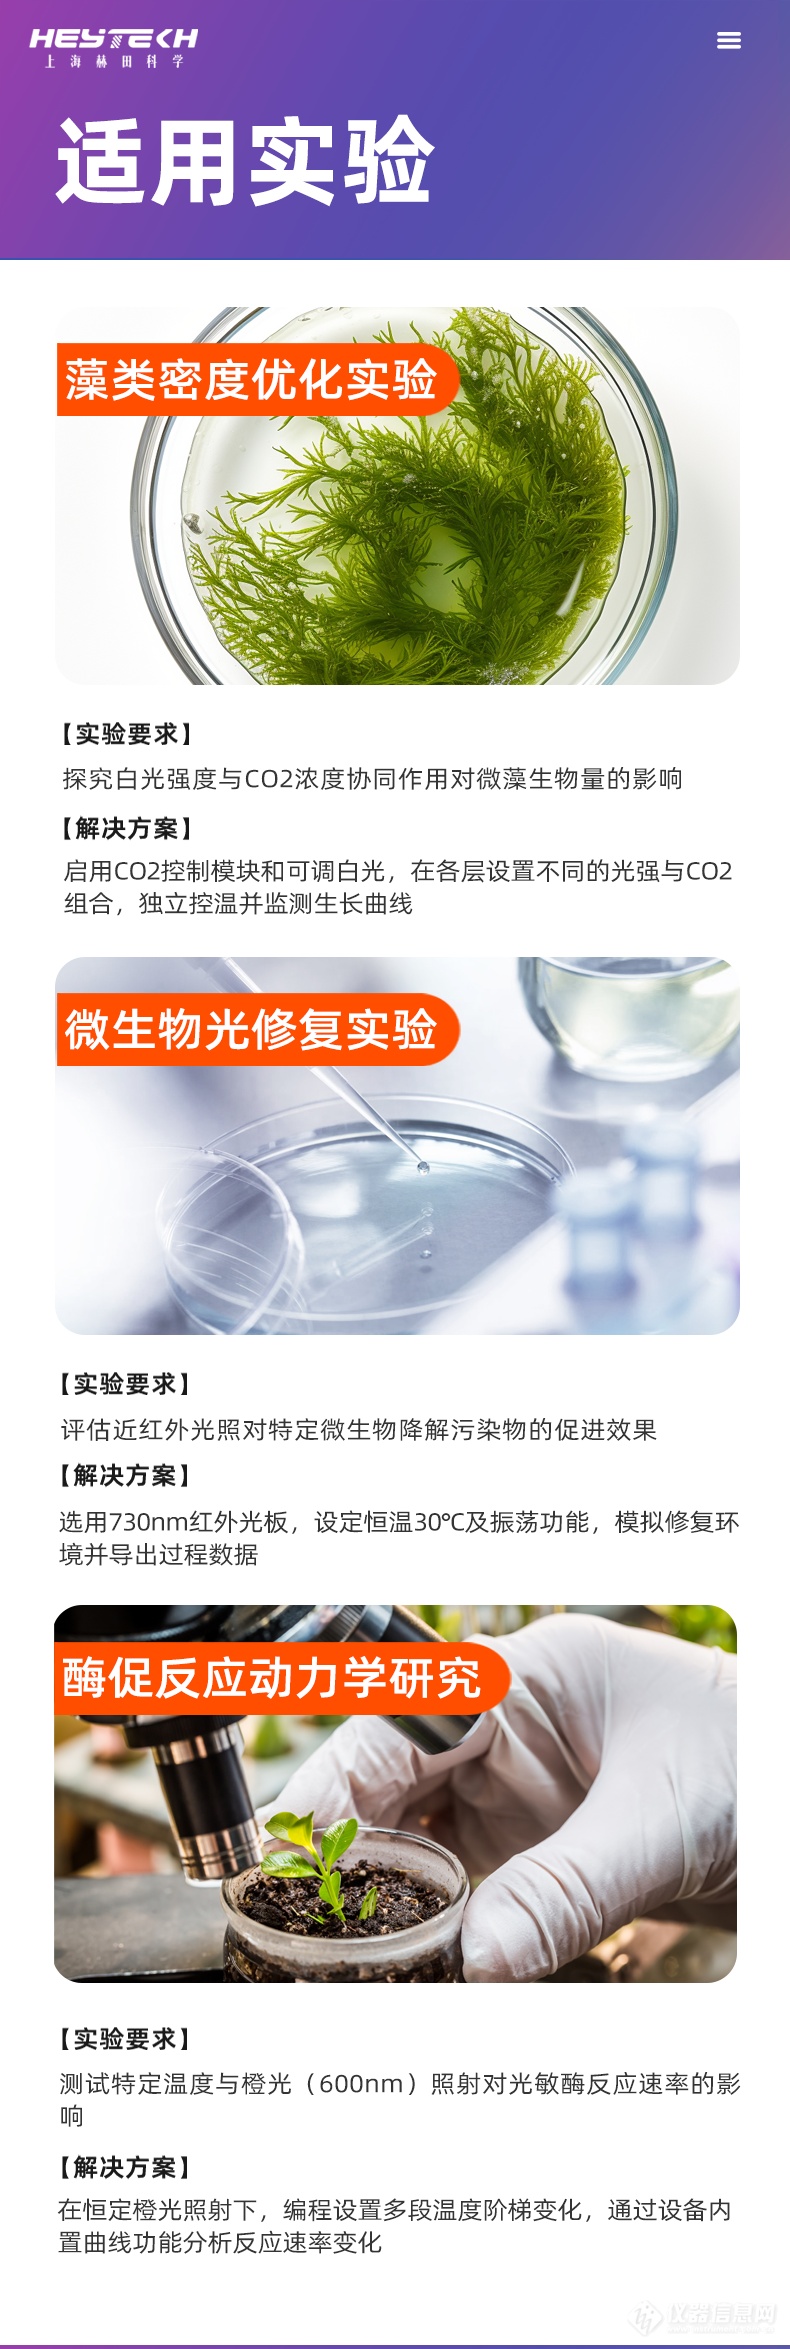

搜索
品牌:上海赫田/Herrytech
产地:上海
型号:YQW-1X100-Z
400-616-7676转2666
核心参数
仪器介绍











详细技术参数一览
产品名称 | YQ-1X100-Z | ||
内胆尺寸 | 500×500×400mm×1层 | ||
外形尺寸 | 880×740×630mm | ||
每层容积 | 100L | ||
控制系统 | 彩色触摸屏,支持编程、预约、曲线查看,具备多级权限密码控制 | ||
温度范围 | 无光照:0~60℃ / 有光照:10~60℃ | ||
温控精度 | 辨析度:0.1℃;波动度:≤±0.5℃;均匀度:≤±0.5℃ | ||
光照强度 (标配) | 0~6000Lx(六级可调),可选配至12000Lx | ||
载物托架 | 每层标配1块(高度可调,可拆卸),可联系客服增配 | ||
电源功率 | 220V, 50Hz,每层700W | ||
定时范围 | 0~9999分钟/小时 | ||
备注 | 提供多种选配项,如紫外杀菌灯、加湿模块等 | ||

可叠加光照摇床、灵活高效,赋能科研创新
在生命科学、农业研究、生物工程等领域的实验中,对培养环境的精确控制是获得可靠数据的关键。传统的大型恒温光照设备往往体积固定、占用空间大,难以灵活适应课题组规模变化或多样化的实验需求。为此,我们全新推出了模块化可叠加光照摇床,以突破性的设计理念,将空间灵活性、独立精准控制与强大扩展功能融为一体,为现代实验室提供了一种高效、智能的解决方案。
一、 核心设计:灵活叠加,独立操控
本产品的最大亮点在于其可自由组合的模块化设计。
1、 按需拓展:您可以根据当前实验规模,选择购置1层、2层或3层设备。它们既可以独立使用,也可以通过稳固的叠加方式,组合成一个多层一体化系统。
2、 独立运行:每一层都是一个完全独立的培养单元,拥有独立的控制系统、加热、制冷和光照系统。这意味着您可以在一台设备上,同时为三个不同的实验设定截然不同的温度、光照和定时程序,互不干扰。
3、 提升空间利用率:垂直叠加的设计,极大地节省了宝贵的实验室台面空间,使单位面积的生产力得到显著提升,尤其适合空间有限的实验室。
三、 卓越性能与智能控制
精准稳定的环境控制:
1、 采用优质全封闭压缩机和加拿大进口终身保修加热丝,制冷制热快速、平稳、可靠。
2、 科学的风道设计配合CESAFE技术,确保箱体内温度均匀稳定(均匀度≤±0.5℃),并有效减少各区域间的交叉污染。
3、 内胆为易于清洁的镜面不锈钢,外壳采用坚固的冷轧钢板喷漆处理。
智能友好的交互体验:
1、 彩色触摸屏直观显示所有运行与设置信息,操作简便。
2、 强大的程序功能:最多可编程50个程序段,进行99次循环,满足复杂培养流程的需求。
3、 全面的定时模式:支持定值运行或多段编程,定时起始点可选择“开机即计时”或“达到设定温度后计时”。
4、 数据管理与安全:具备数据曲线显示、监控、存储及导出功能(需选配)。设有四级密码权限,保障实验参数安全。具备超温报警及自动保护功能。
四、 丰富的功能扩展选项
为满足前沿科研的个性化需求,本设备提供强大的选配功能,轻松升级为全能型实验平台:
1、 远程与通讯:手机APP远程控制、RS485通讯接口。
2、 数据输出:USB数据导出、嵌入式打印机。
3、 振荡培养:集成振荡功能,转速0~300rpm可调。
4、 气体控制:增加CO₂浓度控制系统(0~20%可调)。
5、 高级光照:除标配白光外,可提供更高强度光照(如0-30000/60000Lx),以及多种特定波长LED灯板,涵盖蓝光(450nm)、绿光(520nm)、黄光(580nm)、橙光(600nm)、红光(630/660nm)、近红外(730nm)、远红外(850/940nm),以及UVA、UVB、UVC紫外波段,适用于光生物学、光遗传学等特殊研究。
6、 其他:紫外杀菌灯、加湿模块等。
五、 应用领域
本设备广泛应用于需要精确控制温度、光照、振荡的培养场景,例如:
1、 植物培养:种子发芽、幼苗生长、光周期研究。
2、 微生物培养:藻类、光合细菌的培养与筛选。
3、 昆虫培养:控制昆虫生长周期。
4、 小型生物反应器:微藻培养、发酵初试。
5、 环境模拟:不同光温条件下的材料或生物样本测试。
结语
这款可叠加光照摇床不仅仅是一台设备,更是一个可随科研需求而成长的智能实验平台。它通过模块化设计解决了实验室的空间与灵活性难题,以精准的控制性能和丰富的扩展性,助力研究人员从容应对多样化的实验挑战,加速创新发现。
欢迎联系客服,为您量身定制最适合的实验室培养解决方案!
拨打电话
留言咨询